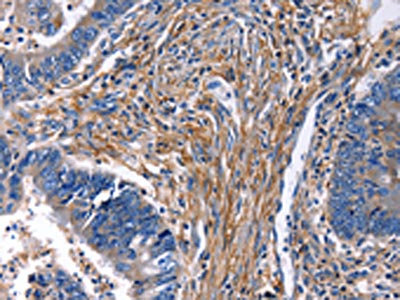

CXCR5 Antibody
-
中文名稱:CXCR5兔多克隆抗體
-
貨號:CSB-PA158258
-
規(guī)格:¥1100
-
圖片:
-
其他:
產(chǎn)品詳情
-
Uniprot No.:
-
基因名:
-
別名:CXCR5; BLR1; MDR15; C-X-C chemokine receptor type 5; CXC-R5; CXCR-5; Burkitt lymphoma receptor 1; Monocyte-derived receptor 15; MDR-15; CD antigen CD185
-
宿主:Rabbit
-
反應種屬:Human
-
免疫原:Synthetic peptide of Human CXCR5
-
免疫原種屬:Homo sapiens (Human)
-
標記方式:Non-conjugated
-
抗體亞型:IgG
-
純化方式:Antigen affinity purification
-
濃度:It differs from different batches. Please contact us to confirm it.
-
保存緩沖液:-20°C, pH7.4 PBS, 0.05% NaN3, 40% Glycerol
-
產(chǎn)品提供形式:Liquid
-
應用范圍:ELISA,IHC
-
推薦稀釋比:
Application Recommended Dilution ELISA 1:1000-1:10000 IHC 1:25-1:100 -
Protocols:
-
儲存條件:Upon receipt, store at -20°C or -80°C. Avoid repeated freeze.
-
貨期:Basically, we can dispatch the products out in 1-3 working days after receiving your orders. Delivery time maybe differs from different purchasing way or location, please kindly consult your local distributors for specific delivery time.
-
用途:For Research Use Only. Not for use in diagnostic or therapeutic procedures.
相關(guān)產(chǎn)品
靶點詳情
-
功能:Cytokine receptor that binds to B-lymphocyte chemoattractant (BLC). Involved in B-cell migration into B-cell follicles of spleen and Peyer patches but not into those of mesenteric or peripheral lymph nodes. May have a regulatory function in Burkitt lymphoma (BL) lymphomagenesis and/or B-cell differentiation.
-
基因功能參考文獻:
- miR-192 suppresses T follicular helper cell differentiation by targeting CXCR5 in childhood asthma. PMID: 29490514
- basal CXCR5(+)Th17 cell frequency may indicate underlying differences in disease phenotype between patients and predict ultimate success of TNF inhibitor therapy PMID: 28004828
- The A allele of rs613791 and G allele of rs523604 located in CXCR5 were observed to be significantly associated with vitiligo in the Chinese Han population. PMID: 28551095
- These results provide clear evidence that CXCR4- or CCR5-beta-arrestin complexes induce receptor endocytosis and signaling in the absence of G protein coupling and ligand-induced conformational changes of the receptor. PMID: 28733085
- these findings demonstrate that CXCR5 overexpression increases the ability of MSCs to respond to migratory stimuli and highly intensifies their immunomodulatory effects in vivo. This strategy for enhancing targeted stem/progenitor cell homing may improve the efficacy of MSC-based therapies. PMID: 28454789
- all three p53 family members mediate the effects of genotoxic stress on the CXCR5 promoter using the same mechanism associated with attenuation of NFkB activity. PMID: 29107083
- identified the miR-19a/CXCR5 pathway as a candidate p53-induced migration mechanism PMID: 28783539
- CXCL13/CXCR5 mediated the aggregation of B cells, that directed the aberrant humoral immune responses via the formation of ectopic germinal centers, which suggests a molecular mechanism of neurological damage in neurosyphilis. PMID: 28931218
- the data demonstrate that CXCR5(+)CD8(+) T cells represent a significant CD8(+) T cell subset in colorectal tumors and have the potential to contribute to antitumor immunity, but their specific roles require further studies in vivo. PMID: 28412245
- we demonstrate that PKCepsilon cooperates with the loss of the tumor suppressor Pten for the development of prostate cancer in a mouse model. Mechanistic analysis revealed that PKCe overexpression and Pten loss individually and synergistically upregulate the production of the chemokine CXCL13, which involves the transcriptional activation of the CXCL13 gene PMID: 28402859
- Levels of CXCR5 mRNA and protein levels were up-regulated in brain from temporal lobe epilepsy patients. PMID: 27873133
- Neoplastic cells of PCSM-TCL are medium- to-large-sized T cells with cerebriform nuclei, which lack the expression of TFH-cell defining chemokine receptor CXCR5. These features are highly distinctive and can be invaluable in separating this rather indolent cutaneous T-cell lymphoid neoplasm from more aggressive lymphomas of TFH-cell phenotype, including primary cutaneous TFH-cell lymphoma and skin involvement of AITL PMID: 26928629
- CXCR5 expression positively related to the lymph node and distal metastasis, tumor stage and relapse of colorectal cancer. PMID: 25726157
- In patients with HBV-related hepatocellular carcinoma the phenotype and function of CXCR5+CD45RA-CD4+ T cells were altered. PMID: 26517519
- HCV infection increased the frequency of CD4+CXCR5+ T cells and decreased the frequency of CD27+IgG+ B cells. CD4+CXCR5+ T cells activated CD27+IgG+ B cells via the secretion of IL-21. PMID: 26818544
- Authors demonstrate that CD40 expression upregulates the chemokine receptor CXCR5 and promotes MDSC migration toward and accumulation within cancer. PMID: 26462153
- down-regulation of CXCR5 inhibited the growth and proliferation of LNCaP cells. PMID: 26640404
- findings reveal a neuronal/astrocytic interaction in the spinal cord by which neuronally produced CXCL13 activates astrocytes via CXCR5 to facilitate neuropathic pain. PMID: 26752644
- Circulating CXCR5+CD4+helper T cells in systemic lupus erythematosus patients share phenotypic properties with germinal center follicular helper T cells and promote antibody production. PMID: 25654980
- study showed that induction of circulating CXCR5+CD4+ Tfh-like subsets can be detected following immunization with HPV vaccines, and potentially be useful as a marker of immunogenicity of vaccines PMID: 26333070
- A negative correlation between levels of miR-346 and percentages of CD4(+)CXCR5(+) T cells was confirmed in Graves' disease PMID: 25666935
- IL-33 enhances humoral immunity against chronic hbv infection through activating CD4(+)CXCR5(+) helper-Inducer T-Lymphocytes. PMID: 25714983
- elevated CXCR5 expression may contribute to abnormal cell survival and migration in breast tumors that lack functional p53. PMID: 25786345
- our findings suggest that CXCL13-CXCR5 axis promotes the growth, migration, and invasion of colon cancer cells, probably via PI3K/AKT pathway PMID: 25476740
- After validation in larger patient groups, CXCR5 and CXCL13 may prove useful as biomarkers for nonsmall cell lung carcinoma Correspondingly, blockade of this axis could serve as an effective therapy for nonsmall cell lung carcinoma. PMID: 25271023
- FANCA-modulated neddylation pathway involved in CXCR5 membrane targeting and cell mobility. PMID: 25015289
- three SNPs (rs497916, rs3922, rs676925) in CXCR5 and one SNP (rs355687) in CXCL13 were associated with hepatitis B vaccine efficacy PMID: 25077417
- specific G protein isoforms coupled to CXCR5 in its resting and active states, were identified. PMID: 23773523
- Expression features of CXCR5 and its ligand, CXCL13 associated with poor prognosis of advanced colorectal cancer PMID: 25010623
- CD4+CXCR5+ helper T cells may contribute to the pathogenesis of primary Sjogren's syndrome by promoting the maturation of B cells. PMID: 24966908
- Suggest that platelet-mediated signaling through CXCR5 may be active in vivo during plaque destabilization, enhancing the anti-inflammatory effects of CXCL13. PMID: 24732574
- healthy controls with rs6421571CT and TT genotypes had higher mRNA and protein levels of CXCR5 than those with wild-type CC genotype specifically in CD4+ T cells PMID: 24833093
- 11q23.3 with rs4938573 near CXCR5 gene is associated with follicular lymphoma. PMID: 25279986
- expression of CXCR5 was significantly associated with both stage and lymph node metastasis, but not with tumor size, tumor differentiation grade, or menopausal status of the patient. PMID: 24337540
- study discovered multiple susceptibility variants for systemic lupus erythematosus in the 11q23.3 region, including variants in/near PHLDB1 (rs11603023), DDX6 (rs638893) and CXCR5 (rs10892301) PMID: 24001599
- Results provide additional evidence for a role of host genetic variation in CXCR5 in lymphomagenesis, particularly for FL. PMID: 23812490
- Data suggest the involvement of CD4+ CXCR5+ T cells (circulating follicular helper T cells Tfh) in the pathogenesis and progression of chronic lymphocytic leukemia (CLL). PMID: 23807677
- Circulating precursor cd4+ T cells expressing CCR7(low)PD-1(high) CXCR5+ indicate T-helper cell activity and promote antibody responses upon antigen re-exposure. PMID: 24138884
- Human circulating memory T-helper cells expressing PD-1 and CXCR5 are highly functional and correlate with broadly neutralizing HIV antibody responses. PMID: 24035365
- A single nucleotide polymorphism in CXCR5, rs630923, is associated with genetic risk for multiple sclerosis. PMID: 23739915
- Polymorphisms in CXCR5 are associated with HIV-associated non-hodgkin B-cell lymphoma. PMID: 23250934
- Interruption of CXCL13-CXCR5 axis increases upper genital tract pathology and activation of NKT cells following chlamydial genital infection. PMID: 23189125
- Data indicate that EBI2 expression modulates CXCL13 binding affinity to CXCR5. PMID: 22913878
- Levels of CXCL13 are increased in carotid atherosclerosis both systemically and within the atherosclerotic lesion. Based on our in vitro findings, we hypothesize a potential plaque stabilizing effects of CXCL13-CXCR5 interaction PMID: 22840692
- C-X-C chemokine receptor type 5 gene polymorphisms are associated with non-Hodgkin lymphoma. PMID: 22707196
- The CXCL13-CXCR5 axis is associated with classic determinants of poor prognosis, such as high grade, hormone receptor negativity, and axillary node involvement. PMID: 22607768
- Sections of the mouse CXCR5 intron significantly align plus/plus with sections of the human intron; the aligned segments are in the same order in mouse as in man and overall cover 13% of the mouse sequence and 17% of the human sequence. PMID: 20809769
- Data indicate that the percentages of CD4(+)CXCR5(+) TFH in IA patients were positively correlated with AST. PMID: 21750724
- these results add new information about the CXCL13-CXCR5 axis in neuroblastic tumors and in the crosstalk between neuroblastic and stromal cells. PMID: 21642390
- Central memory CD4 T cells expressing CXCR5 efficiently induced PC differentiation and Ig secretion, and displayed a different profile in terms of cytokine and costimulatory molecule expression. PMID: 21471443
顯示更多
收起更多
-
亞細胞定位:Cell membrane; Multi-pass membrane protein.
-
蛋白家族:G-protein coupled receptor 1 family
-
組織特異性:Expression in mature B-cells and Burkitt lymphoma cells.
-
數(shù)據(jù)庫鏈接:
Most popular with customers
-
-
YWHAB Recombinant Monoclonal Antibody
Applications: ELISA, WB, IHC, IF, FC
Species Reactivity: Human, Mouse, Rat
-
Phospho-YAP1 (S127) Recombinant Monoclonal Antibody
Applications: ELISA, WB, IHC
Species Reactivity: Human
-
-
-
-
-